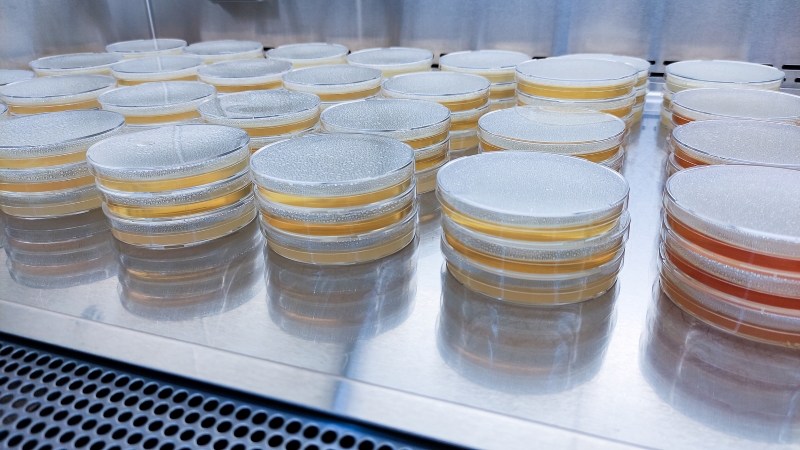

O agitador incubador é um equipamento indispensável em laboratórios biológicos, muito utilizado para o cultivo de microrganismos, células e tecidos, bem como em experiências que envolvam fusão, solidificação, dissolução e penetração de substâncias. Controla com precisão a temperatura e a velocidade de oscilação, proporcionando um ambiente estável para as experiências e garantindo a fiabilidade dos resultados.

Uma característica fundamental de uma incubadora agitadora é a sua capacidade de promover o processo de cultura através da oscilação. Seja reciprocante ou rotativa, o principal objetivo da oscilação é aumentar o fornecimento de oxigénio na solução, o que é crucial para a respiração celular em culturas aeróbias. A oscilação permite que o meio de cultura entre em contacto total com o oxigénio, melhorando o fornecimento de oxigénio dissolvido e, por sua vez, aumentando a uniformidade do crescimento celular ou bacteriano e a eficiência da cultura. Como resultado, os agitadores de incubação são amplamente utilizados na triagem de estirpes, na expansão de culturas microbianas e nos campos de investigação em ciências biológicas, como a fisiologia microbiana, a bioquímica e a fermentação. São ferramentas essenciais nos processos de cultura laboratorial.
O oxigénio nos líquidos à base de água, como os meios de cultura, é dissolvido como um gás. A quantidade de oxigénio dissolvido é influenciada por vários fatores. Em primeiro lugar, a quantidade de oxigénio dissolvido é diretamente proporcional à pressão parcial de oxigénio no ar. Quanto maior for a pressão parcial de oxigénio, mais oxigénio é dissolvido na água. Em segundo lugar, a quantidade de oxigénio dissolvido é inversamente proporcional à temperatura da água. A temperaturas mais elevadas, a solubilidade do oxigénio diminui, resultando em menos oxigénio dissolvido; a temperaturas mais baixas, a solubilidade aumenta, resultando em mais oxigénio dissolvido. Por exemplo, a 20°C, 100 volumes de água podem dissolver 3 volumes de oxigénio, o que é aproximadamente 21,4 mg por litro; a 0°C, 100 volumes de água podem dissolver 5 volumes de oxigénio, o equivalente a cerca de 35,7 mg por litro.

Além disso, a profundidade da água também afeta a quantidade de oxigénio dissolvido. Quanto mais profunda for a água, menor será o teor de oxigénio. Isto acontece porque o oxigénio entra na água principalmente através da difusão atmosférica, que ocorre da superfície para camadas mais profundas. Quanto maior for a profundidade, menor será a pressão atmosférica na água, reduzindo a quantidade de oxigénio que pode penetrar. Da mesma forma, a área da superfície da água influencia o nível de oxigénio dissolvido. Quanto maior for a área da superfície, mais oxigénio se pode difundir na água.
Com mais de dez anos de experiência a trabalhar com utilizadores, Welso descobriu que a temperatura de cultura celular ou de bactérias está dentro de um intervalo específico, o que significa que a temperatura por si só não afeta significativamente o teor de oxigénio dissolvido. Além disso, a pressão parcial de oxigénio no ar permanece relativamente constante e tem um impacto limitado nos níveis de oxigénio dissolvido. Assim sendo, para aumentar o teor de oxigénio dissolvido, os fatores-chave são a profundidade do meio de cultura e a sua área de contacto com o ar. Como resultado, é crucial selecionar o frasco de agitação, a amplitude rotacional e a velocidade corretas.
Durante a rotação, a força centrífuga empurra o líquido para a parede da garrafa, o que não só reduz a profundidade do líquido, como também aumenta a área de superfície em contacto com o ar, aumentando efetivamente o teor de oxigénio dissolvido. Este processo permite que o agitador forneça às células ou bactérias um fornecimento mais abundante de oxigénio, promovendo o seu crescimento e reprodução.
F = m×ω2*r
A força centrífuga do meio de cultura no frasco de cultura que está a ser rodado:
F = m×ω2*r

Os agitadores incubadores Welso oferecem duas opções de amplitude: 26 mm e 50 mm. Para garrafas pequenas (menos de 500 ml), escolha 26 mm com uma velocidade mais elevada, e para garrafas maiores (mais de 1000 ml), selecione 50 mm com uma velocidade mais baixa.
Quando a força centrífuga no líquido é igual à da amplitude de 26 mm e 50 mm
M*ω12*26/2= m*ω22*50/2
Então a relação entre ω1 e ω2 é:
ω1≈1.4ω2
Ou seja, 50 amplitude 100rpm é basicamente equivalente a 26 amplitude 140rpm.

Ao ajustar adequadamente os parâmetros de oscilação, o agitador incubador pode criar um ambiente de cultura otimizado para várias condições experimentais, tornando-o amplamente utilizado em microbiologia, cultura celular e outros campos de investigação biológica.
Seguir a conta oficial